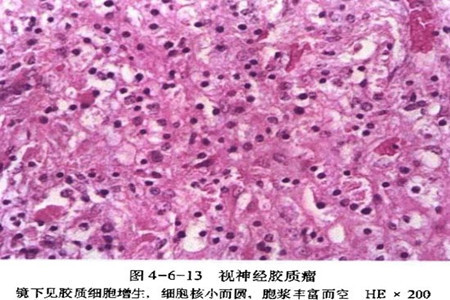
儿童胶质瘤最佳治疗方法,儿童胶质瘤的最佳治疗方法

视路胶质瘤(optic pathway glioma,OPG)是起源于视神经、视交叉、视束或下丘脑的低级别星形细胞瘤,严重影响患者的视力及内分泌功能。好发于儿童(<18岁),约10%的患者≥19岁。
OPG好发部位与年龄无明显相关,但可能影响预后,累及视神经的总病死率约为5%,而累及下丘脑的病死率约50%,患者的生命质量较差。由于OPG的临床病程变异较多,加之患者年龄较小,治疗方式的选择较为困难。
目前,临床上对于OPG的治疗主要有外科手术治疗、放疗和化疗以供选择。

1、手术治疗
手术的作用是延缓药物治疗时对神经发育造成的毒性效应,尤其是年龄偏小的患儿。随着小儿神经外科技术的发展,目前手术治疗可以在最大程度切除肿瘤的同时保留功能。
手术可以缓解患儿脑积水等颅高压症状,并行活检可以明确肿瘤病理类型。而一项多学科共识声明认为,部分经化疗或放疗失败的OPG患儿,手术治疗可以控制或者延缓肿瘤进展[5]。总之,手术治疗OPG可以控制肿瘤进展,还可以明确肿瘤的病理类型。
临床一般认为当OPG患者出现单侧视神经受累导致眼球突出,影响容貌、失明或二者同时存在;视交叉外生型导致占位效应或脑积水时应考虑手术。当患者出现视交叉弥漫性受累或广泛浸润性病变是手术的相对禁忌证。
据统计,仅有视神经受累的OPG患儿,大部切除肿瘤预后良好,15年随访的生存率为92%,对于位于视交叉后的病变,单纯手术切除后10年的无进展生存率仅为41%。
2、化疗
目前认为化疗的作用在于延缓或者避免采用有潜在长期毒性的治疗手段(如放疗)。化疗并不能完全改善OPG患儿的视力。虽然化疗可减小或者控制肿瘤的体积,保留或改善患儿视力及内分泌功能,但是效果并不理想。由于缺少靶向性的化疗药物,所以目前化疗只能作为病情进展时延迟放疗或手术的补充手段。
3、放疗
目前OPG的治疗原则是尽可能延缓放疗的应用。关于治疗对OPG的治疗方法,最常用的是外放射治疗,其中最经典的是三维适形放疗,尤其调强保护重要的组织结构,但须考虑正常组织所能耐受的剂量。目前最优化的治疗方法是直线加速器为基础的立体定向多分割放疗,这种方式可以精确定位肿瘤边界。
需要注意的是,合并NF1的OPG患儿继发内分泌功能障碍、发育障碍、认知功能障碍及血管增生疾病的风险要显著高于散发的OPG患儿[41]。
对于肿瘤进展或视力恶化的OPG患儿来说,放疗是最有效的治疗方式,年龄较大的OPG患儿,疗效及预后较幼儿好,但年龄是否影响预后目前尚无文献报道,有待进一步研究。有报道发现主要接受治疗的OPG患儿,其视力预后优于放疗前接受过化疗的患儿,肿瘤减压术加放疗可能会保留或改善OPG患儿的视力。

4、预后
与中枢神经系统其他肿瘤相比,儿童OPG若能接受最佳方案的治疗,一般预后较好。但是对于伴发NF1的OPG患儿,对治疗的反应仍存在不确定性,因此如何选择治疗方案仍不乐观。通过系统性回顾发现,与病情进展相关的危险因素包括:发病时年龄<1岁,同时不合并NF1,视神经通路上偏后的病变。
内分泌功能障碍是OPG最常见的后遗症,主要的原因是肿瘤本身,好发于累及下丘脑的患儿,小部分由于治疗引起。常见症状如性早熟、生长障碍等。OPG放疗后遗症,最严重的可能是脑血管增生,如烟雾病。
总而言之,儿童OPG是低度恶性胶质瘤,目前关于其治疗尚没有形成统一的认知,但是国内对于严格选择的患儿,采用手术部分切除加放疗的治疗策略,取得了较好的疗效,当然还需要更长期的随访观察,以防出现潜在的不良反应。